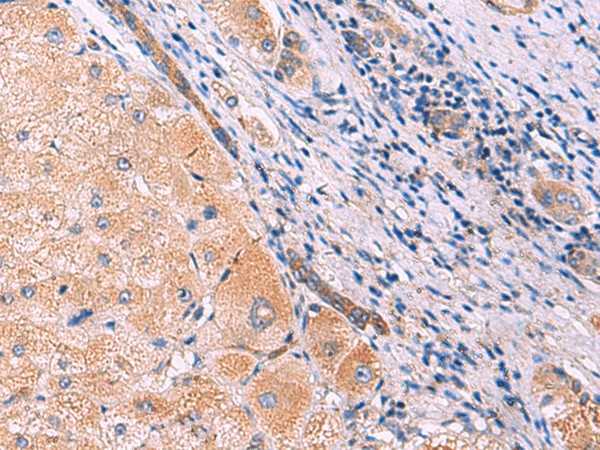
Валидация Elabscience E-AB-52979

| UNIPROT | Q9UBF9 |
| Иммуноген | Гибридный белок, соответствующий человеческому MYOT |
MYOT Polyclonal Antibody (E-AB-52979)
Реактивность подтвержденная:
человек, мышь
Источник (хозяин):
кролик
Валидировано для:
IHC
WB
Характеристики
Техническое описание
| Каталожный номер | E-AB-52979 |
| Название антигена | Myotilin (MYOT) |
| UNIPROT | Q9UBF9 |
| Иммуноген | Гибридный белок, соответствующий человеческому MYOT |
| Английские синонимы | LGMD1, LGMD1A, TTID, Myotolin, Myofibrillar Titin-Like Protein, TiTin Immunoglobulin Domain, Limb-Girdle Muscular Dystrophy 1A, 57 kDa cytoskeletal protein |
Реактивность подтвержденная Нужна другая реактивность? |
человек, мышь |
| Источник (хозяин) | кролик |
| Изотип | IgG |
| Клональность | поликлональное |
| Рекомбинантное | нет |
| Готовое к использованию | нет |
| Концентрация | 1.2 мг/мл |
| Конъюгат | нет |
| Валидировано для | IHC WB Иммуногистохимия; Вестерн-блоттинг |
| Рекомендуемые разведения | WB 1:1000-1:5000; IHC 1:50-1:300 |
| Метод очистки | Аффинная очистка с антигеном |
| Состав буфера | PBS с 0.05% NaN3 и 40% глицерин,pH7.4 |
| Условия доставки | термобокс с аккумуляторами холода |
| Условия хранения | Хранить при -20°C - 12 месяцев. Избегать повторяющихся циклов замораживания/оттаивания |
| Срок хранения | 12 месяцев |
| Производитель | Elabscience |
| Ссылка на страницу товара на сайте производителя | https://www.elabscience.com/p-myot_polyclonal_antibody-e_ab_52979 |
|
Артикул
|
Наименование |
Производитель
|
|---|
|
Артикул
|
Наименование |
Производитель
|
|---|
|
Артикул
|
Наименование |
Производитель
|
|---|
|
Артикул
|
Наименование |
Производитель
|
|---|
Акции и предложения
Популярные продукты:
Myelin Basic Protein/MBP Antibody (AF4085)
Источник (хозяин): кролик
Реактивность подтвержденная: человек, мышь, крыса
Валидировано для: IHC, WB, IF, ICC
Реактивность подтвержденная: человек, мышь, крыса
Валидировано для: IHC, WB, IF, ICC
Anti-Human SCD Polyclonal Antibody (PHA19301)
Источник (хозяин): кролик
Реактивность подтвержденная: человек
Валидировано для: ELISA, IHC, WB
Реактивность подтвержденная: человек
Валидировано для: ELISA, IHC, WB
Anti-Human NOXO1 Polyclonal Antibody (PHP15601)
Источник (хозяин): кролик
Реактивность подтвержденная: человек
Валидировано для: ELISA, WB
Реактивность подтвержденная: человек
Валидировано для: ELISA, WB
Bovine Astrocytic phosphoprotein PEA 15(PEA15) ELISA kit (E11A1941)
Организм: корова
Anti-SMAD4 Polyclonal Antibody (PHG55201)
Источник (хозяин): кролик
Реактивность подтвержденная: человек, мышь, крыса
Валидировано для: ELISA, IHC, WB
Реактивность подтвержденная: человек, мышь, крыса
Валидировано для: ELISA, IHC, WB
Anti-OAT Polyclonal Antibody (PHC07301)
Источник (хозяин): кролик
Реактивность подтвержденная: человек, мышь, крыса
Валидировано для: ELISA, IHC, WB
Реактивность подтвержденная: человек, мышь, крыса
Валидировано для: ELISA, IHC, WB